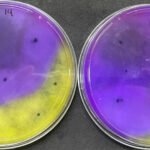

Extrato da planta Artemisia annua melhora imunidade e ganho de peso da tilápia
Produto melhora a saúde intestinal dos peixes. Extrato contribui para melhorar ganho de peso. É capaz de minimizar a necessidade de uso de antibióticos ao fortalecer o sistema imunológico do animal. Promove alterações na morfologia intestinal, resultando em melhor conversão alimentar e eficiência proteica. Um novo produto baseado nessa planta está...
Procon Tocantins notifica 123 Milhas para oferecer outras opções de ressarcimento aos consumidores
A Superintendência de Proteção e Defesa do Consumidor do Tocantins (Procon Tocantins) notificou nesta terça-feira (22) a empresa 123 Milhas, para que ofereça outras formas de ressarcimento aos consumidores. A empresa, que comercializa passagens e pacotes de viagens com transferência de milhas, suspendeu a execução de pacotes promocionais na última sexta-feira, 18. As viagens...
MERCADOPreços do boi gordo: atacado sobe graças a consumo aquecido Quanto à arroba, alguns frigoríficos ensaiam elevação de preços, mas de forma pontual
MERCADOPreços do boi gordo: atacado sobe graças a consumo aquecido
Quanto à arroba, alguns frigoríficos ensaiam elevação de preços, mas de forma pontual
Fonte: Canal Rural
Adapec conclui ciclo de vigilância sorológica e clínica de suínos em propriedades rurais no Tocantins
Estudo de vigilância sorológica e clínica em suínos foi realizado em 132 propriedades selecionadas de 73 municípios do Tocantins
- Foto: Keven Lopes/Governo do Tocantins
A Agência de Defesa Agropecuária (Adapec) encaminhou nesta terça-feira, 13, para o laboratório, as últimas 57 amostras, das 593 coletas feitas no estudo de vigilância sorológica e clínica em suínos, nas...
Cantora Simone será a principal atração na festa do aniversário de 34 anos de Palmas
A cantora Simone Mendes, ex-integrante da dupla Simone e Simaria, será a principal atração na festa de comemoração dos 34 anos de Palmas. O evento acontecerá no dia 19 de maio na Praia da Graciosa, véspera do aniversário, celebrado no dia 20.Um palco será montada na Orla da Graciosa para receber os palmenses. Segundo...
veja como fecharam os preços da arroba hoje
O mercado físico do boi gordo apresenta relativa acomodação em seus preços, enquanto o ambiente de negócios ainda sugere por alguma elevação no curto prazo em estados como São Paulo e Mato Grosso, informa a consultoria Safras & Mercado.
“O Pará começa a se deparar com encurtamento das escalas de abate em algumas regiões...
Conselho Deliberativo da APA Lago de Palmas dá posse a conselheiros
Reunião de Conselho deu posse a novos conselheiros para o biênio 2023-2025
- Foto: Andréa Marques Paz/Governo do Tocantins
Para tratar da revisão do Regimento Interno, dar posse aos novos conselheiros e apresentar as ações desenvolvidas no 1º semestre de 2023, o Instituto Natureza do Tocantins (Naturatins) promoveu nessa quarta-feira, 30, a reunião ordinária do...
Pesquisa desenvolve cenoura híbrida para o verão
Além da resistência à queima-das-folhas, BRS Carmela é tolerante ao nematoide-das-galhas, permitindo o cultivo em regiões de temperaturas mais altas. Resistência faz a nova cenoura chegar ao fim do ciclo de produção sem nenhum controle químico para doenças foliares. A menor necessidade de insumos químicos contribui para a sustentabilidade ambiental e...
Fungos do solo eliminam o mofo-branco, que afeta soja, feijão e algodão
Pesquisadores identificam fungos do gênero Trichoderma que inibem 100% o mofo-branco Doença é uma das principais ameaças para cultivos como soja, feijão e algodão. Alternativa biológica reduz dependência de fungicidas químicos. Pesquisa destaca potencial do biocontrole e da integração com outras boas práticas agrícolas. Mercado de biopesticidas cresce com demanda por soluções...
Governo do Tocantins intensifica fiscalização e promove educação ambiental nas praias do extremo sul do Estado
Fiscalização ambiental do Naturatins dialoga com famílias sobre a importância da preservação ambiental
- Foto: Lidiane Moreira/Governo do Tocantins
O Governo do Tocantins, por meio da fiscalização do Instituto Natureza do Tocantins (Naturatins), em parceria com a Defesa Civil Municipal de Paranã, no extremo sul do Tocantins, concluiu neste final de semana, uma fiscalização conjunta nas...